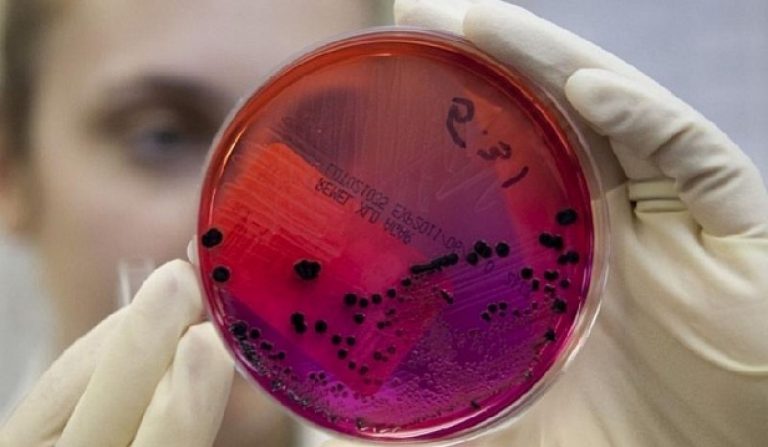

Актуальный статус пересмотра ISO 9001:2026 и ожидаемые изменения
Вступление Стандарту, являющемуся основой для систем менеджмента качества (СМК) во всем мире, присвоен статус пересмотра ISO 9001. Новая версия, ISO 9001:2026, призвана учесть современные вызовы, включая цифровизацию, устойчивое развитие и усиление ...
Форум “ВСЁ ПОД КОНТРОЛЕМ !”
Альянс Групп с радостью приглашает пищевиков на весенний Форум “ВСЁ ПОД КОНТРОЛЕМ”! Мы посвятили Форум актуальным вопросам контроля рисков по качеству и безопасности продуктов питания. Форум “ВСЁ ПОД КОНТРОЛЕМ!” — ...
Сальмонелла – что важно знать пищевику?
Сальмонелла. Методические указания по обнаружению сальмонелл в продуктах подготовил Роспотребнадзор МУ 4.2.4070—24. Сальмонеллы обладают высокой устойчивостью к воздействию различных факторов внешней среды. В жидкой среде при прогревании до температуры плюс ...
Корпоративный тренинг в Агрокомплексе имени Н. И. Ткачёва
Построение СМБПП в животноводческих комплексах. Яркое солнце и живые эмоции прямиком из Краснодарского края! Прямо сейчас проводим корпоративный тренинг в Агрокомплексе имени Н. И. Ткачёва! #Доверие Отдел качества и производственно-ветеринарного ...
Рейтинг нарушений по стандарту FSSC 22000 v. 6
Что нужно знать В конце ноября был опубликован рейтинг нарушений по стандарту FSSC 22000 v. 6, в котором фонд поделился важной статистикой нарушений, которые чаще всего выявлялись на аудитах пищевых ...
Культура пищевой безопасности 2024: итоги Форума.
1 октября 2024 года в отеле Золотое кольцо прошёл ежегодный Форум “Культура пищевой безопасности 2024”. Форум посетили производители пищевых продуктов, представители торговых сетей и сферы быстрого питания. Многие компании понимают ...
Сезон лучших курсов по FSSC 6.0 и ISO 22000
Только этой осенью сезон лучших курсов по FSSC 22000 v. 6.0 и ISO 22000 с Лучшими тренерами Учебного центра "Альянс" пройдут во всех возможных форматах. Найдите свой Формат и пройдите обучение на доступном и понятном языке.
КУЛЬТУРА ПИЩЕВОЙ БЕЗОПАСНОСТИ 2024
Практический форум: КУЛЬТУРА ПИЩЕВОЙ БЕЗОПАСНОСТИ И КАЧЕСТВА 2024. Ведётся активная регистрация. Компания Альянс Групп приглашает Вас на свой ежегодный форум «Культура пищевой безопасности — 2024», который пройдёт в г. Москва. ...
Комос Групп учится в Альянс.
Новости от учебного центра “Альянс” прямиком из Ижевска! Недавно мы провели корпоративный тренинг для внутренних аудиторов холдинга “Комос Групп“. На тренинге собрались представители разных сегментов агрохолдинга – производство молока и ...
FSSC и требования ISO 22000 по климату. Разъяснения.
Фонд FSSC опубликовал разъяснения по часто возникающим вопросам о применении поправки к стандарту ISO 22000:2018. Требования ISO 22000 по климату. Внесенные изменения стандарта ISO 22000:2018 коснулись оценки рисков по изменению климата.
Новый ТР ТС на пищевые добавки
27 февраля 2024 года в России и других странах Таможенного союза начнёт действовать новая версия ТР ТС на пищевые добавки (техрегламента 029/2012). Разработка новой версии ТР заняла 8 лет. С учётом ...
Сезон лучших курсов по FSSC 6.0 и ISO 22000
Только этой осенью сезон лучших курсов по FSSC 22000 v. 6.0 и ISO 22000 с Лучшими тренерами Учебного центра "Альянс" пройдут во всех возможных форматах. Найдите свой Формат и пройдите обучение на доступном и понятном языке.
График вебинаров на 2023 год
Дорогие друзья – Представляем Вашему вниманию График вебинаров на первое полугодие 2023 года. График онлайн вебинаров учебного центра Альянс включает все самые востребованные и актуальные темы для обучения специалистов пищевых ...
Скоро Новый ГОСТ Р 70231-2022
1 сентября 2023 года начнёт действовать ГОСТ Р 70231-2022. Его название: «Одежда для работников производства пищевой продукции и общественного питания. Требования, основанные на принципах ХАССП»
FSSC 24000
В октябре Фонд FSSC выпустил совершенно новый стандарт FSSC 24000 – Сертификация Систем Социального Менеджмента. В основу легли требования Стандарта PAS 24000 (BSI). Фонд дополнил их правилами сертификации и руководствами ...
С профессиональным праздником!
Дорогие коллеги, поздравляем всех с праздником работника пищевой промышленности!Здоровья, мира, внутреннего Дзена нам всем))И конечно, терпения и успеха в Вашем деле, которое объединяет и вдохновляет, Российский Пищепром – лучший! Взаимные ...
Госпрограммы поддержки
12 марта Учебный центр Альянс совместно с международным органом по сертификации CSI, Центром Мой Бизнес и Международной Промышленной Академией проводит круглый стол для презентации Госпрограммы поддержки “Государственное финансирование сертификации систем ...
Форум по пищевой безопасности 2021.
9 февраля 2021 года состоится он-лайн Форум по пищевой безопасности 2021: “ПИЩЁВКА 2021: ЗАКОНЫ, ПОДДЕРЖКА, РАЗВИТИЕ” – Уникальная дискуссионная площадка России по вопросам пищевой безопасности. Онлайн-платформа мероприятия включает в себя функции ...
Антивирусные вебинары
Время повышать интеллектуальный иммунитет! Приглашаем на наши антивирусные вебинары. Уважаемые партнеры, коллеги, друзья! Мы знаем, что многие из вас сейчас оптимизируют свои бизнес-процессы для удаленной работы. И уверены, что многие ...
5 версия FSSC 22000
FSSC 22000 является ведущей схемой сертификации систем менеджмента пищевой безопасности. Схема основана на стандарте ISO 22000, к которому добавлены требования Global Food Safety Initiative (GFSI). GFSI, одна из влиятельных групп ...
“Органический” закон
С 1 января 2020 года вступил в силу Закон об органической (экологически чистой) продукции. Впервые вопросы по регулированию производства органически чистой сельхозпродукции стали появляться в России еще в конце 1990-х. ...
Перечни стандартов к ТР/ТС
Коллегия ЕЭК утвердила актуализированные перечни стандартов к ТР/ТС «О безопасности пищевой продукции». Коллегия Евразийской экономической комиссии (ЕЭК) 24 декабря рассмотрела вопросы в сферах таможенно-тарифного, таможенного и технического регулирования, транспорта, интеграции, ...
Исследование трансглютаминазы
В систему государственного мониторинга Россельхознадзора будет включено исследование на наличие микробной трансглютаминазы В 2020 году в реализацию планов государственных работ и мониторинга пищевой безопасности Россельхознадзора планируется включить контроль пищевых продуктов ...
Тренинг Черкизово
В ноябре в нашем учебном центре стартовали новые программы обучения внутренних аудиторов по пятой версии FSSC для компании Черкизово. Совместно с Департаментом по работе с персоналом Управляющей компании Птицеводство Группы Черкизово мы провели ...
ИИ для Меркурия
Разработана модель использования искусственного интеллекта (ИИ для Меркурия) во ФГИС «Ветис», модуль «Меркурий» В рамках программы «Руководитель цифровой трансформации для высшего звена» (Chief digital transformation officer, CDTO), состоялась успешная защита ...
Внутренние аудиторы УК Дамате
Самая яркая часть нашего курса Внутренний аудит системы пищевой безопасности – это стажировка. Полученные в ходе обучения теоретические знания мы предлагаем закрепить на практике под наблюдением и руководством тренера, который ...
Технические условия ISO TS 22002-5
Опубликованы технические условия для хранения и транспортировки пищевых продуктов ISO TS 22002-5 (2019) ISO 22000 – один из самых популярных международных стандартов в области безопасности пищевых продуктов. В нём содержатся ...
Эфиры жирных кислот – нормирование в пище.
Решением Коллегии Евразийской экономической комиссии от 06.08.2019 № 132 внесены изменения в Единые санитарно-эпидемиологические и гигиенические требования к продукции (товарам), подлежащей санитарно-эпидемиологическому надзору (контролю), предусматривающие установление нормативов глицидиловых эфиров жирных ...
Технический регламент на рыбу
Технический регламент на рыбу и рыбную продукцию вступил в силу – Завершен переходный период. В странах Евразийского экономического союза (ЕАЭС) прекратили свое действие переходные положения техрегламента на рыбную продукцию. «В ...
Тренинг по FSSC 22000
Новосибирская Шоколадная Фабрика: Проведён корпоративный тренинг по FSSC 22000 Для тех компаний, которые самостоятельно готовятся к сертификации на соответствие FSSC 22000 наш Учебный Центр Альянс разработал курс по корпоративному обучению ...
Тренинг по ISO 9001 в ТАКФ
После вступления в силу стандарта ISO 9001:2015 для многих организаций стал актуальным вопрос доработки системы менеджмента качества, функционирующей в организации до соответствия требованиям новой версии стандарта. Некоторые требования стандарта вводятся ...
ГК «Дамате» с УЦ Альянс!
Компания Дамате запустила программу обучения совместно с учебным центром Альянс Группа компаний «Дамате» запустила программу обучения по системе пищевой безопасности. Программа стартовала в июле и продлится до ноября текущего года. ...
Персонал и его обучение.
Обеспечение пищевой безопасности на предприятиях является основной задачей, предъявляемой к производителям как со стороны потребителей, так и со стороны государства. Обучение персонала по пищевой безопасности – Одна из главных целей ...
Стандарты на рыбу
В ЕАЭС будут разработаны новые межгосударственные стандарты на рыбу и рыбную продукцию. Коллегия Евразийской экономической комиссии (ЕЭК) рассмотрела вопросы в сферах: Коллегия ЕЭК утвердила Программу разработки межгосударственных стандартов к техническому ...
Пищевая безопасность в логистике
Безопасность пищевых продуктов обеспечивается за счет предотвращения, устранения и контроля опасностей на всех этапах цепи их создания (от производства до потребления). Так как опасности для безопасности пищевых продуктов могут возникнуть ...
Молоко на “Меркурий”. Часть 2
С 1 июля 2019 года в систему электронной ветеринарной сертификации «Меркурий» планируется включить готовую молочную продукцию. А с 1 ноября 2019 года запланировано добавление готовой кисломолочной продукции Решение о включение ...
Новая версия ISO 22000:2018
Новая версия ISO 22000:2018 была утверждена и вступила в силу с 19 июня 2018. В новой версии стандарта ISO 22000: 2018 применяется структура высокого уровня ISO (HLS – анг. High Level Structure), ...
Молоко на “Меркурий”. Часть 1
Вице-премьер Алексей Гордеев поручил министерствам и ведомствам доработать проект постановления правительства о маркировке готовой молочной продукции и обеспечить ее интеграцию с системой обязательной ветеринарной сертификации “Меркурий”. Об этом ТАСС сообщили ...
Корпоратив Татспиртпром
1 – 2 апреля 2019 года наш Учебный Центр провел двухдневный тренинг внутренних аудиторов компании “Татспиртпром” по теме: “ISO 22000:2018. Обзор стандарта системы менеджмента безопасности пищевых продуктов”. ISO 22000 – это стандарт, устанавливающий ...
Изменение законодательства
Изменение законодательства в 2018 году произошло, в том числе, и в пищевом секторе. Но изменения коснулись не только Российской Федерации, но и затронут страны ЕАЭС: внесены изменения в технические регламенты ...
Тренинг “Работа с персоналом”
Сегодня производители понимают, что залогом создания работоспособной Системы пищевой безопасности может быть только осознанное вовлечение сотрудников в системную работу. Тренинг “Работа с персоналом” даст им понимание целей и принципов пищевой ...
Фальсификация и защита продукции
Фальсификация и защита продукции при производстве пищевых продуктов вызывает беспокойство среди производителей и становится все более актуальной темой. Компании теряют деньги, а потребители утрачивают доверие. По оценкам специалистов, в результате ...
МАКФА: Корпоративное обучение
19 июня 2018 года Международная организация по стандартизации ISO опубликовала долгожданную обновленную версию своего стандарта для систем менеджмента безопасности пищевых продуктов – ISO 22000. Компания “Макфа” является одним из обладателей ...
Краснобор – Корпоративное обучение
Система управления безопасностью пищевых продуктов будет эффективной, если люди, отвечающие за ее функционирование, будут компетентными. Этого можно достичь периодические проводя Корпоративное обучение. Регулярное обучение способствует вовлеченности персонала в поддержании и ...
Тренинг ТОП-менеджеров КОМОС ГРУПП
В отличие от других видов бизнеса, продовольственные компании подвержены специфическим рискам, связанным с безопасностью их продукции, которые могут уничтожить компанию за один день. Тренинг ТОП-менеджеров таких компаний направлен на систематизацию ...
Обучение цехового персонала
Независимо от вида пищевого бизнеса, будь то мясокомбинат, молочный завод или ресторан, продукт создают люди, которые каждый день на всех уровнях компании должны соблюдать соответствующие процедуры. Обучение цехового персонала – ...
Корпоратив в РПК “Хмелёфф”
Русская пивоваренная компания “Хмелёфф” прошла обучение в Учебном Центре Альянс В начале июля Учебный центр Альянс провел выездной тренинг. Учились руководители и ключевые специалисты компании “Русская пивоваренная компания “Хмелёфф”. В ...
Тренинг по поточности и зонированию.
Тема предотвращения перекрестного загрязнения по-прежнему актуальна для производителей. Тренинг по поточности и зонированию поможет в решении насущных вопросов. Как показывает практика, с проблемами в этом вопросе сталкиваются даже те предприятия, которые ...
ФЗ об органической (ЭКО) продукции
Федеральный закон от 03.08.2018 N 280-ФЗ “Об органической продукции и о внесении изменений в отдельные законодательные акты Российской Федерации” Установлено, что при производстве органической (ЭКО) продукции должны соблюдаться определенные требования. ...
Молоко. Эксперимент с маркировкой.
Правительство России планирует провести эксперимент по маркировке отдельных видов молочной продукции (в него войдут молоко и прочие молочные продукты) в период с 1 сентября 2018 года по 31 декабря 2019 ...
Мобильное приложение от “Меркурий”
Одна из IT-компаний – партнеров Россельхознадзора – Такском разработала мобильное приложение, которое позволяет с мобильных устройств исполнять несколько весьма полезных функций в рамках электронной ветеринарной сертификации “Меркурий“. Скачать приложение, которое называется Такском-ВетИС ...
КОНФИТУР – Международный форум
4 – 5 июля в Санкт-Петербурге прошла международная конференция “КОНФИТУР-2018”, которая объединила производителей кондитерских изделий, глазури, начинок, отечественных и зарубежных экспертов отрасли, производителей и поставщиков оборудования, технологий и ингредиентов для ...
Обновлен стандарт ISO 19011
На официальном сайте ISO в июле 2018 года опубликована 3 версия стандарта ISO 19011:2018. Название стандарта “Руководящие указания по аудиту систем менеджмента”. Он разработан комитетом ISO / PC 302 и ...
Перечни подконтрольных товаров
В перечни подконтрольных товаров внесены изменения, выводящие из под ЭВС ряд подконтрольных товаров. Приказ Минсельхоза РФ от 27 июня 2018 г. № 249 “О внесении изменений в перечень продукции животного происхождения, ...
Совместный семинар по работе в системе Меркурий с X5 Retail Group
С 1 июля 2018 года все организации и ИП, которые имеют дело с продукцией животного происхождения, должны применять систему “Меркурий”. Подключиться к системе должны не только производители продукции и оптовики, ...
С Днем Рыбака!
Только представьте себе… Краборыбоконсервная флотилия – огромный плавучий завод по добыче и переработке морепродуктов. Прямо в океане. 20 000 сотрудников. 86 судов. Из 32 лет производственного стажа 16 на самом ...
Обучение аудиторов Дикси
В апреле текущего года началось наше сотрудничество с федеральной розничной сетью “Дикси”. Основная задача, которая стояла перед Учебным центром – обучение внутренних аудиторов компании в корпоративном формате, систематизирование знаний в ...
Законопроект о маркировании животных
Минсельхоз подготовил изменения в законопроект “О ветеринарии”, предусматривающий введение маркирования и учета животных. Данный законопроект размещен на сайте regulation.gov.ru. “Законопроектом вводятся понятия маркирования и учета животных. Указанные процессы направлены на обеспечение прослеживаемости животных ...
Штрафы за неприменение «Меркурий»
7 июня на Федеральном портале проектов нормативных правовых актов был размещен текст проекта федерального закона, предусматривающий внесение изменений в статью 10.8 Кодекса Российской Федерации об административных правонарушениях. В частности, проектом предлагается отменить ...
Новые формы проверочных листов
Федеральная служба по ветеринарному и фитосанитарному надзору информирует о государственной регистрации Минюстом России 03 мая 2018 года приказа Россельхознадзора от 19 марта 2018 года «Об утверждении форм проверочных листов (списков ...
BRC Food Safety v 8
01.08.2018 г. будет опубликована BRC Food Safety v 8 международного стандарта по пищевой безопасности Global Standard for Food Safety. Он разработан Британским консорциумом розничной торговли (British Retail Consortium — BRC). Аудит ...
Изменения в маркировке алкогольной продукции
С 1 июля 2018 года вступают изменения в маркировке алкогольной продукции. Федеральным законом от 28.12.2017 № 433-ФЗ “О внесении изменений в Федеральный закон “О государственном регулировании производства и оборота этилового ...
В Краснодаре состоялась IV Конференция по пищевой безопасности для поставщиков торговых сетей
17 апреля состоялась IV Конференция поставщиков торговых сетей в Краснодаре по развитию, которая стала уникальной площадкой для открытого и конструктивного диалога поставщиков, представителей торговой сети и экспертов-аудиторов. Организаторы – Учебный центр ...
Изменения в ТР ТС: Информирование о растительных жирах.
Изменения в ТР ТС “О безопасности молока и молочной продукции”. Информирование о растительных жирах. Коллегия ЕЭК установила переходные положения по изменениям в техрегламент Союза «О безопасности молока и молочной продукции». ...
ФГИС “Меркурий” – семинар по внедрению
По просьбам наших клиентов и партнеров Учебный центр Альянс организовал семинар по внедрению на предприятиях электронной ветеринарной сертификации ФГИС “Меркурий”. В семинаре приняло участие свыше 70 компаний и 100 специалистов ...
Friesland Campina: Внутренние аудиторы учатся в Альянсе.
Компания Friesland Campina обратилась в наш учебный центр для проведения корпоративного обучения внутренних аудиторов. Анастасия Васкевич, менеджер по сертификации компании Friesland Campina, отметила следующее: Перед нами стояла непростая задача в сжатые ...
Кондитерский комбинат АКУЛЬЧЕВ: тренинг по новой версии FSSC 22000.
АКУЛЬЧЕВ: тренинг по новой версии FSSC 22000. В июле 2017 года владельцы схемы сертификации FSSC 22000 опубликовали новую версию 4.1. Новая версия отражает важнейшие векторы развития систем менеджмента пищевой безопасности ...
Корпоративное обучение Сочинского мясокомбината по пищевой безопасности.
Успех внедрения и функционирования Систем менеджмента зависит от осознанной вовлеченности сотрудников и руководителей в процесс становления Системы. Корпоративное обучение Сочинского мясокомбината настроило процессы компании в нужном направлении. Известно, что люди ...
Новые правила эксплуатации зданий, помещений для хранения и переработки сельхозпродукции.
С 1 марта начинают действовать новые правила эксплуатации зданий и помещений для хранения и переработки сельскохозяйственной продукции. Свод правил “Здания и помещения для хранения и переработки сельскохозяйственной продукции. Правила эксплуатации” ...
Новая версия стандарта IFS Logistics.
Стандарт IFS Logistics – версии 2.2 хорошо известен российским пользователям. Сегодня многие логистические компании, в том числе российские, получают международный сертификат IFS Logistics. Требования клиентов – ритейлеров, сетевых рестораторов, да и ...
Новые правила маркировки «молочки» с растительными жирами вступят в силу в июле.
Новые правила маркировки, которые ужесточают требования к содержанию растительных жиров в молочной продукции, в Российской Федерации вступят в силу в июле. Об этом сказал министр сельского хозяйства Александр Ткачев на ...
Тренинг для производителей пищевой упаковки.
Учебный центр Альянс провёл корпоративное обучение Протэк. Все материалы, которые входят в контакт с пищевыми продуктами, особенно пищевая упаковка, могут влиять на пищевую безопасность. Как не в состоянии защитить пищевые ...
О нормировании содержания трансизомеров жирных кислот в продуктах питания.
C 1 января 2018 года вступил в силу после переходного периода новый норматив. Теперь регламентируется содержание трансизомеров жирных кислот в масложировой продукции (технический регламент Таможенного союза ТР ТС 024/2011 «Технический ...
Президент России подписал закон о переносе обязательной электронной ветеринарной сертификации на полгода.
Владимир Путин подписал федеральный закон «О внесении изменений в статью 4 Федерального закона «О внесении изменений в Закон Российской Федерации «О ветеринарии» и отдельные законодательные акты Российской Федерации»», предусматривающий перенос срока ...
Обучение технических специалистов в компании КРРОС
Управление техобслуживанием оборудования и инженерных систем – одна из составляющих системы пищевой безопасности. Корпоративное обучение КРРОС по данной теме было проведено Учебным центром Альянс. Требование к обслуживанию оборудования установлено в ...
Схема сертификации FSSC 22000. Внутренний аудит.
Традиционно в конце ноября, перед тем, как предновогоднее увеличение объемов производства поглощает все заводы страны, в нашем учебном центре проходит курс “Схема сертификации FSSC 22000. Система пищевой безопасности на основе НАССР-анализа. ...
Агропродмаш: “Меркурий”: точка невозврата.
В этом году в центре внимания участников деловой программы международной выставки «Агропродмаш» оказалась система «Меркурий». Бурное обсуждение развернулось на площадке VII международного мясного конгресса, посвященного внедрению электронной ветеринарной сертификации. В ...
Тренинг для технической дирекции Птицефабрики Удмуртская.
Удмуртская птицефабрика для рабочей группы НАССР провела корпоративное обучение своей технической дирекции. Им, как и для любого предприятия не обойтись в своем составе без технических специалистов. Кто, как не они ...
Конференция для поставщиков торговых сетей ПФО.
12 октября 2017 года состоялась конференция поставщиков в ПФО. Мероприятие прошло в столице ПФО – в городе Нижнем Новгороде. В ходе работы конференции эксперты и производители обсудили актуальные требования торговых сетей ...
ГК Черкизово: обучение персонала мясоперерабатывающих площадок
Наш учебный центр на протяжении многих лет является партнером Группы Компаний Черкизово в сфере обучения персонала системам пищевой безопасности. Девизом этого мероприятия стало: “В Черкизово СМБПП”. В этом году начата ...
Тренинг по новой версии FSSC 22000 состоится 14 ноября.
22 декабря 2016 года международный Фонд FSSC 22000 опубликовал новую версию стандарта FSSC 22000 (version 4). Тренинг по новой версии проводит Учебный центр Альянс. Некоторые ключевые изменения включают в себя ...
Корпоративное обучение в HAME.
Знаменитая чешская продуктовая компания НАМЕ выбрала наш Учебный Центр Альянс для обучения персонала Системам пищевой безопасности. Предприятие занимается переработкой мяса, томатной пасты, овощей и фруктов. Головной офис предприятия находится в ...
Есть вопрос по электронной ветеринарной сертификации? Задавайте!
В 2018 году электронная ветеринарная сертификация (ЭВС) станет обязательной для всех участников рынка. Процесс ее внедрения вызвал широкий резонанс общественности. “Есть вопрос”? В связи с этим Россельхознадзор предлагает направить интересующий ...
Открытый тренинг по международному стандарту FSSC 22000.
На этой неделе в нашем учебном центре состоялся очный тренинг по международному стандарту FSSC 22000 для специалистов предприятий по производству продуктов питания. Очный тренинг вела преподаватель курса – Дианова Наталья. Является ...
Начало внедрения ЭВС – 1 июля 2018 года.
Дворкович отложил начало внедрения ЭВС до 1 июля 2018 года. В рамках совещания о подготовке к введению системы электронной ветеринарной сертификации А.В. Дворкович поручил: Минсельхозу России и Россельхознадзору: Совместно с заинтересованными федеральными ...
Новые стандарты установят требования к консервированным овощам, фруктам и грибам.
Федеральным агентством по техническому регулированию и метрологии (Росстандарт) 25 августа 2017 г. утверждены национальные новые стандарты в области переработки фруктов, овощей и грибов. ГОСТ 34110-2017 «Фрукты, овощи, грибы и продукты ...
Интеграция “Меркурий” и 1С.
Евгений Колобов: «Интеграция “Меркурий” и 1С должна гарантировать корректность ввода данных и их сохранность». Руководитель Комитета государственного ветеринарного надзора Нижегородской области Евгений Алексеевич Колобов рассказал порталу «Ветеринария.рф» о достижениях и трудностях ветеринарной ...
Приняты ветеринарные правила по сибирской язве.
Принят приказ, регламентирующий ветеринарные правила по сибирской язве. Министерство сельского хозяйства Российской Федерации от 14.08.2017 № 403 «Об утверждении Ветеринарных правил осуществления профилактических, диагностических, лечебных, ограничительных и иных мероприятий, установления и ...
Технический регламент ЕАЭС “О безопасности рыбы и рыбной продукции”.
1 сентября вступил в силу Технический регламент ЕАЭС “О безопасности рыбы и рыбной продукции”. И текущая неделя началась с тренинга НАССР для рыбоперерабытывающих предприятий с учетом требований вышеупомянутого ТР 040/2016. ...
Страны ЕАЭС – опережающее развитие.
ЕАЭС определили требования мировых лидеров в области рыбопереработки! C 1 сентября 2017 года вступает в силу Технический регламент Евразийского экономического союза «О безопасности рыбы и рыбной продукции» (ТР ЕАЭС 040/2016). ...
Постановление Правительства.
Постановлением Правительства России от 17 августа 2017 года № 974 о доставке рыбных ресурсов. Устанавливается порядок доставки ресурсов, добытых в Баренцевом, Балтийском, Чёрном и Азовском морях. Улов, добытый на данных территориях ...
Миграция веществ из упаковки.
Опубликовано Руководство, указывающее на то, как происходит миграция веществ из упаковочных материалов в продукты питания. Британским консорциумом предприятий розничной торговли (British Retail Consortium – BRC) опубликовано первое издание Глобального Руководства по ...
Перечень поручений Президента.
Президент утвердил перечень поручений по итогам совещания с членами Правительства Российской Федерации, состоявшегося 28 июля, касающийся превентивных мер по африканской чуме свиней и других вопросов. Согласно документу, Правительству Российской Федерации ...
Штрафы за нарушения техрегламентов.
По итогам процедуры оценки регулирующего воздействия Министерство экономического развитие дало положительную оценку проекту закона “О внесении изменений в КоАП в части усиления административной ответственности за нарушение требований технических регламентов, предъявляемых ...
Роль ветеринарной службы.
Ассоциация «Ветбезопасность» продолжает переводить положения Кодекса здоровья наземных животных МЭБ. Сегодня мы рассмотрим роль ветеринарной службы в экспертизе продуктов питания и пищевой безопасности в целом. Этому важному вопросу посвящена глава 6.1 ...
Корпоративный тренинг FSSC 22000 для сотрудников “АНГСТРЕМ Трейдинг”
Корпоративный тренинг сотрудников “АНГСТРЕМ Трейдинг”. А мы тем временем отправляемся с нашим бизнес-тренером Ирина Шилова в один из самых любимых городов – Санкт-Петербург к одним из самых любимых партнеров – Агрохолдинг “АФГ ...
Всемирный день чистых рук.
Всемирный день чистых рук проводится 15 октября. Этот день призван напомнить людям о влиянии мытья рук на здоровье, сделать эту процедуру естественной, как дома, так и вне его. Решение о ...
День работника сельского хозяйства.
Дорогие друзья, коллеги! Поздравляю всех работников отечественного агропромышленного комплекса с профессиональным праздником – Днем работника сельского хозяйства и перерабатывающей промышленности! Окончание сельскохозяйственных работ для нас – традиционно не только праздник. ...